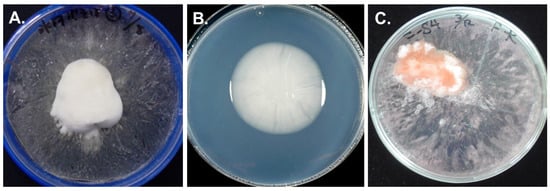
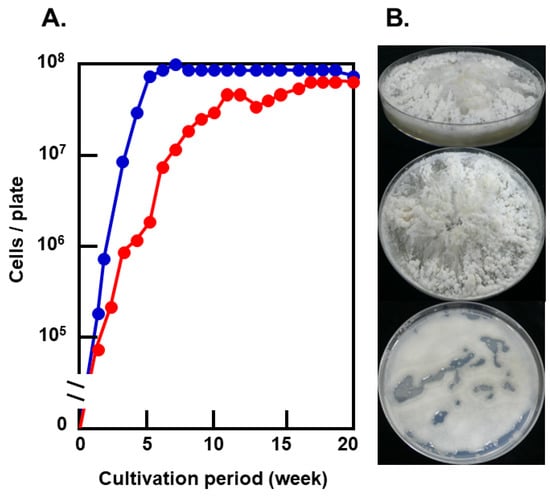

Abstract
The basidiomycetous yeast, Glaciozyma antarctica, was isolated from various terrestrial materials collected from the Sôya coast, East Antarctica, and formed frost-columnar colonies on agar plates frozen at −1 °C. Thawed colonies were highly viscous, indicating that the yeast produced a large number of extracellular polysaccharides (EPS). G. antarctica was then cultured on frozen media containing red food coloring to observe the dynamics of solutes in unfrozen water; pigments accumulated in frozen yeast colonies, indicating that solutes were concentrated in unfrozen water of yeast colonies. Moreover, the yeast produced a small quantity of ice-binding proteins (IBPs) which inhibited ice crystal growth. Solutes in unfrozen water were considered to accumulate in the pore of frozen colonies. The extracellular IBPs may have held an unfrozen state of medium water after accumulation in the frost-columnar colony.
1. Introduction
Even in the continental Antarctic region, which represents one of the coldest places in the world, various eukaryotic microorganisms are known to exist. Isolated basidiomycetous fungi in this region occurred in yeast-form except for alien species [1], and basidiomycetous yeasts were dominant among culturable fungal strains in the McMurdo Dry Valley [2] and the ice-free area of the Lützow-Holm Bay [3,4,5,6]. Basidiomycetous yeasts have belonged in Pucciniomycotina, Ustilaginomycotina, and Tremellomycetes in Agricomycotina. Tremellomycetes and Agaricomycetes (known species were filamentous form) were detected in soils near glacial lakes in the McMurdo Dry Valley [7] and Victoria Land [8] by DNA metabarcording, and Tremellomycetes were the dominant taxa in these areas. DNA metabarcording suggested that Coprinellus and Pleurotus (both in Agaricomycetes) were included in dominant fungal taxa on rocks in the polar desert of the Ellsworth Mountains [9].
Previously, we described that ecophysiological strategies for freezing tolerance of filamentous fungi differed among taxa in in the Northern Hemisphere [10]. Filamentous basidiomycetes such as Typhula ishikariensis secreted abundant ice-binding proteins (IBPs) (>95% of total extracellular proteins) [11] to keep the extracellular environment unfrozen. This fungus also produced extracellular polysaccharides (EPS) which covered the hyphae to inhibit the diffusion of IBPs so that thermal hysteresis activity may be maintained [10]. However, in basidiomycetous yeasts, there are few reports on frost resistance.
Several cold-adapted yeasts, including basidiomycetes, could grow under freezing conditions [12,13] because they were exceptionally well adapted to cold environments where they thrived in combinations of several stressful conditions [8,14,15]. Among basidiomycetous yeasts, trehalose and glycerol are well-known frost protectants in yeasts, and trehalose accumulated in the cytoplasm in Mrakia spp. and Leucosporidium spp. to reduce the freezing point of the cytoplasm [16,17]. Biosynthesis pathways of glycerol, trehalose, polyamines, and aromatic amino acids in M. blollopis were accelerated under freezing temperatures [18]. Polyamines and aromatic acids are recognized to function to support cell growth under low temperatures. However, low temperatures caused glycerol accumulation instead of trehalose in M. psychrophila [19].
IBPs or their activities were recorded in basidiomycetous yeasts in Pucciniomycotina, such as Glaciozyma antarctica (syn. Leucosporidium antarcticum [20,21,22], Leucosporidium sp. [23], L. creatinivorum [24], Psychromyces glacialis (‘Rhodotorula svalbardensis’) [25], Rhodotorula glacialis [20]; Tremellomycetes such as Goffeauzyma gastrica (syn. Cryptococcus gastricus) [24]. However, Mrakia spp. in Tremellomycetes could not produce IBPs [20], and draft genome analysis of M. blollopis suggested that strain SK-4 did not have IBP genes [26]. Therefore, Mrakia spp. were less frost tolerant to freeze-thaw cycles among basidiomycetous yeasts isolated from Antarctica [24].
In this article, we isolated the basidiomycetous yeast, G. antarctica, which formed irregular frozen colonies like frost columns at subzero temperatures and elucidated their growth mechanism on frozen media. Our results indicated that G. antarctica had unique physiologic characteristics against freezing stress to adapt to continental Antarctica.
2. Materials and Methods
2.1. Sample Collection and Fungal Isolation on Frozen Media
Various terrestrial samples such as soil, mosses, and algal mats were collected from eight ice-free areas in the Coasts of Sôya and Prince Harald, and Lützow-Holm Bay, East Antarctica from December 2006 to February 2007 (Figure 1). Samples were collected using disposable γ-ray sterilized spatulas or autoclaved tweezers and were kept in γ-ray sterilized plastic bags. Sample types are shown in Table S1, and collected samples were stored at −20 °C before isolating fungi that grew on frozen potato dextrose agar (PDA, Becton, Dickinson and Company, Sparks, MD, USA) plates cultured according to Hoshino et al. [27]. Samples, each weighing 100 mg, were placed on PDA plates and frozen at −80 °C for 24 h. Frozen plates were transferred to −1 °C for six months. Fungi that grew on frozen PDA were transferred and maintained on PDA slants at 4 °C.

Figure 1.
Locations of sampling sites and various terrestrial samples in this study. (A) Sampling sites: I: Ongul Is., II: Langhovde, III: Skarvsnes, IV: Skallen, V: Rundvågshetta. (B) Example of sampling sites and collected samples: soils in East Ongul Is. (B-1,2), moss colonies in Skarvsnes (B-3), algal mats from the bottom of freshwater lakes in Skarvsnes (B-4), dried algal mats (B-5), and dead birds near freshwater lakesides in Skarvsnes (B-6).
2.2. Phylogenic Analysis
DNA was extracted from 2–5 fungal isolates, each with similar morphological characteristics and grown on frozen PDA, according to the protocol of Isoplants II Kit (Wako Pure Chemical Industries, Osaka, Japan). The internal transcribed spacer (ITS) region of genomic rDNA was amplified with the primer pairs ITS1F [28] and ITS4 [29]. LSU rDNA D1/D2 domain of 5 yeast isolates that formed frost-columnar colonies on PDA were also amplified with the primers ITS1F and NL4 [30]. PCR products were purified using QIAquick PCR Purifications Kit (Qiagen, Hilden, Germany) and sequenced on an ABI PRISM 3100 Genetic Analyzer (Applied Biosystems, Foster City, CA, USA) using primers ITS1F (ITS region of tested isolates) and ITS1F, ITS4, NL1 and NL4 (ITS region and D1/D2 domains of G. antarctica formed frost-columnar colonies).
Multiple alignments of ITS region and D1/D2 domain sequences were performed using CLUSTAL W (http://clustalw.ddbj.nig.ac.jp/) (access on 26 July 2021) and manually adjusted. A phylogenic tree was constructed by the Maximum parsimony method and using the program MEGA X [31] with bootstrap values based on 1000 replications.
2.3. Morphological Analyses on Frost-Columnar Colonies
One loopful of cells of G. antarctica S4B was inoculated on a frozen PDA plate including 0.05% (w/v) red food color (Kyoritsu Foods Co., Tokyo, Japan) and was incubated at −1 °C for two months. Three plates were used for this experiment in triplicate. Surface features of frost-columnar colonies were observed by scanning electron microscopy (SEM). Frost-columnar colonies were lyophilized and coated with platinum-palladium using JFC-1100 Ion Sputter (JEOL, Tokyo, Japan). They were examined using JSM-T330A SEM (JEOL, Tokyo, Japan) operating at 15 kV.
2.4. Chemical Analyses of EPS
Strain S4B was inoculated on frozen or unfrozen PDA plates (regular, 1/2, 1/5, and 1/10 nutrient conditions). Three plates were used for each experimental condition in triplicate. Frost-columnar colonies on PDA were thawed and suspended in water. Yeast cells were removed by centrifugation (15,000× g, 20 min at 2 C). HPLC determining the molecular mass of polysaccharides in the supernatant was performed according to Yoshida et al. [32], and sugar composition was analyzed following Matsuyama et al. [33].
2.5. IBP Activity in Frost-Columnar Colonies and Culture Broth
The frozen colony of G. antarctica S4B on PDA was thawed at 4 C and suspended in 10 mL of 0.1 M ammonium bicarbonate (pH 7.9). Yeast cells and EPS were removed by centrifugation (15,000× g, 20 min at 2 C). The supernatant was washed three times by 0.1 M ammonium bicarbonate (pH 7.9) and concentrated by the ultrafiltration to SDS-PAGE and immunoblotting by anti-Typhula ishikariensis IBPs antibody [34]. SDS-PAGE followed the methods of Laemmli [35]. Immunoblotting analysis was made using the ECL Western Blotting Detection System (Cytiva, Tokyo, Japan).
Fifty milliliters of each of G. antarctica S4B, Coprinus psychromorbidus [36], and T. ishikariensis BRB cultures were prepared by inoculating two loopfuls of cells of G. antarctica S4B or two mycelial discs (5 mm in diam), cut from the margin of an actively growing colony on a PDA plate, into potato dextrose broth and then incubating for 3 months at −1 °C without shaking. Yeast cells were removed by centrifugation (15,000× g, 20 min at 2 C), and mycelia were also removed by filtration.
The IBP activity of the concentrated supernatant was examined on the development of ice crystals under a Leica DML 100 photomicroscope (Leica Microsystems AG, Wetzlar, Germany) equipped with a Linkam LK600 temperature controller (Linkam, Surrey, UK) [37]. Each experiment was tested in triplicate.
2.6. Statistical Analysis
Relationships between frost-columnar colonies and sampling sites or sample types were analyzed using ANOVA and Tukey’s HSD test (significant for p < 0.05).
3. Results and Discussion
3.1. Fungal Growth on Frozen Media
Several filamentous fungi and yeasts grew from terrestrial samples inoculated at −1 °C on frozen PDA plates (Table 1). Of 277 samples examined, 166 showed mycelial growth, and frost-columnar colonies occurred in 37 samples (details of isolates are shown in Table S2). There was no relationship between sample type and fungal occurrence.

Table 1.
The number of fungi that grew on frozen potato dextrose agar, including those that formed frost-columnar colonies.
Some colonies on frozen PDA were irregular in shape and resembled frozen “marshmallows” in appearance (Figure 2A). We named these frozen colonies “frost-columnar colonies”, and all these colonies were included in white yeasts. Five isolates of these yeasts among frost-columnar colonies were identified as G. antarctica since they were highly homologous to the ITS region and D1/D2 domains of G. antarctica CBS 5942T (Figure S1), and the phylogenetic tree was a similar morphology as previously recorded [38]. G. antarctica was exclusively isolated from them and formed the same colonies in aseptic cultures of frozen PDA (Figure 2C). We used the S4B strain isolated from soil in East Onglu Is. for later experiments, and we did not observe that other fungal isolates without G. antarctica formed frost-columnar colonies in our experimental condition.
Figure 2.
Colonies of G. antarctica at subzero temperature. Soil near Hyoga-Ike (glacier pond) in Landvode was inoculated on frozen PDA at −1 °C for 3 months (A). S4B strain was isolated from soil in East Onglu Is. Their growth on unfrozen PDA at −1 °C for 1 month (B) and frozen PDA, including red food coloring for 2 months (C).
Thawed colonies were highly viscous due to a large amount of carbohydrates, which were identified by the phenol sulfuric acid method. HPLC analysis revealed that the carbohydrates were polymerized hexoses (30–100 molecules) composed of ca. 69% D-glucose, 30% D-galactose, and 1% D-mannose.
3.2. The Structure of Frozen Colonies
During the growth of the yeast on frozen PDA containing red food coloring, the pigment was concentrated in the frozen colony (Figure 2C). This result suggested that frozen colonies accumulated unfrozen water containing red food coloring and other solutes in PDA. The surface of the colony was frosted and pale pink, but inside the colony, pigmentation became intense to the interface with PDA (Figure 3A). The colony was lyophilized to investigate its structure by SEM. The surface had honeycomb-like structure (Figure 3B), and the center was porous like a sponge (Figure 3C). There were large holes in the bottom (Figure 3D,E). Yeast cells were suspended in the hole by EPS or attached to the wall of the hole (Figure 3F).

Figure 3.
The structure of G. antarctica colony on frozen PDA. Cut surface of the colony on frozen PDA containing red food coloring (A). The honeycomb structure of the colony surface (B). Sponge-like structure of the center (C). Longitudinal section of the bottom (D,E). Close-up view of the rectangular in E. * Holes. Bars 100 μm (B–D), 50 μm (E), and 10 μm (F).
3.3. Cell Growth and EPS Production on Frozen Media
The colonies of G. antarctica on frozen PDA looked like frost columns, while on unfrozen PDA, the colonies were typical of yeast colonies (Figure 4B). While cell growth on frozen PDA culminated in 108 cells/plate after 17 weeks, the maximal cell growth was attained after 5 weeks on unfrozen PDA (Figure 4A). EPS content in the frost-columnar colonies decreased to ca. 1/5 when colonies were kept at −1 °C for 1 year (material not intended for publication: Seiichi Fujiu, Graduate School of Science, Hokkaido University, Sapporo, Japan, Master thesis entitled “Studies on environmental adaptation of Antarctic basidiomycetous yeast formed frost-columnar colonies under frozen conditions” in Japanese, 2010). Therefore, EPS produced by the yeast also acted as a storage material for their growth.
Figure 4.
Growth of G. antarctica at −1 °C on PDA. (A). Growth of G. antarctica on unfrozen PDA (blue) and frozen PDA (red). (B). Frozen PDA cultures at −1 °C for 20 weeks (top and middle) and unfrozen PDA cultures at −1 °C for 5 weeks (bottom).
Glaciozym antarctica is known to produce EPS abundantly [39]. Cultural conditions had a significant influence on the EPS productivity of G. antarctica. EPS productivity on frozen PDA was 50 to 100 times higher than that on unfrozen PDA, and EPS productivity was highest on 1/2 frozen PDA (Figure 5). Nutrients in the culture decreased by half on 1/10 frozen PDA after 20 weeks.

Figure 5.
Effect of cultural conditions on extracellular polysaccharide productivity of G. antarctica S4B. Cultures were incubated at −1 °C for 20 weeks on frozen PDA or 5 weeks on unfrozen PDA. Error bars indicated SD (n = 3).
Basidiomycetous yeast Mrakia blollopis changed their morphology under different nutrient conditions [40]; M. blollopis showed yeast cells on eutrophic media and hyphal cells on oligotrophic media. Filamentous growth allows fungi to explore a more excellent surface search for water and nutrients and makes it possible to form aggregates to retain water and nutrients in unconsolidated and sandy soils [8]. On the other hand, G. antarctica kept the yeast-form under the conditions tested. On frozen PDA, the cell growth of G. antarctica was delayed, but maximal cell numbers attained on frozen PDA were the same as those on unfrozen PDA. These results suggested that G. antarctica adapted well to the frozen environment but that their physiological characteristics were not osmophilic or xerophilic.
3.4. IBP Activity in Frozen Media
Extracellular IBP activity of G. antarctica was found from culture broth [20,21]. Expressions of IBP genes in G. antarctica PI12 were induced by subzero temperatures under an unfrozen condition [21,41]. Arctic diatoms in sea ice avoid freezing through thermal hysteresis by IBP and EPS [42]. We also observed a distorted hexagonal bipyramidal shape of ice crystals based on IBP activity from extracellular fractions of frost-columnar colonies (Figure 6A). The molecular mass of major proteins in extracellular fractions was >30 kDa (Figure 6B), similar to the molecular mass of Afp4 (one of the isoforms of IBPs) in G. antarctica PI12 [22]. This major protein was immunoreacted with the anti-Typhula ishikarienis antibody (Figure 6C). Extracellular IBP productivity of G. antarctica S4B was less than those of basidiomycetous snow molds, T. ishikariensis and C. psychromorbidus (Figure 6D).

Figure 6.
IBPs in both the frozen colony and culture of G. antarctica strain S4B. Development of ice crystal in the extracellular fraction from frost-columnar colony (A). SDS-PAGE of the extracellular fractions from frost-columnar colony with Coomassie Brilliant Blue staining (B) Immunoblotting of the extracellular fractions from frost-columnar colony and SDS-PAGE of culture broths of G. antarctica strain S4B and other basidiomycetes (C). Molecular marker (lane 1), the extracellular fractions from frost-columnar colonies (lane B2, C2 and D4), culture broth of Pichia pastoris without TisAFP gene (negative control; lane B3), culture broth of P. pastoris transformed TisAFP6 gene [43] (positive control; lane B4), culture broth of Coprinus psychromorbidus (lane D2), and culture broth of T. ishikariensis BRB (lane D3). Forty μL of the extracellular fractions and culture broths were loaded on lanes 2–4, respectively.
Both filamentous basidiomycetes produced extracellular IBPs abundantly (>90–95% of total extracellular proteins) to adapt to freezing environments; however, T. ishikariensis may inhibit mycelial growth at subzero temperatures when IBPs freely diffuse into the extracellular environment [10,27]. Possibly, IBP molecules are bound with EPS, covering the mycelia of T. ishikariensis to protect from freezing damage [10]. Both basidiomycetes, G. antarctica and T. ishikariensis, produce both EPS and IBPs for frost resistance, but the ratios of EPS to IBPs were contrasting; G. antarctica produced a large amount of EPS and a small amount of IBPs to form frozen colonies. While T. ishikariensis always develops mycelia, G. antarctica exists in the form of yeast. Such a difference in the life form of both fungi implies that they adopted different strategies to adapt to frozen environments. Further investigations on other fungi are necessary to generalize the hypothesis.
4. Conclusions
We found that the basidiomycetous yeast, G. antarctica, produced a large amount of EPS and developed frost-columnar colonies on frozen PDA. These frozen colonies were porous, and yeast cells were found aligned along the walls of the pores. We considered that unfrozen water containing nutrients was accumulated within the pores of frozen colonies through the capillary phenomenon and the Marangoni effect by EPS, and that yeast cells absorbed nutrients in liquid water for growth. IBP was detected in frozen colonies. IBPs in frozen colonies of G. antarctica may keep accumulated water in the liquid state.
Glaciozyma antarctica in continental Antarctica and T. ishikariensis in the Boreal zone were well adapted to subzero temperatures to utilize EPS and IBPs. However, while T. ishikariensis applied these substances to control the micro-environment around their mycelia under supercooling conditions, G. antarctica applied these substances to absorb nutrients in liquid water under freezing conditions, indicating that both fungi used the same substances for different purposes.
Supplementary Materials
The following are available online at https://www.mdpi.com/article/10.3390/microorganisms9081679/s1, Table S1: Sample type to use in this study, Table S2: Fungal isolates grown on frozen PDA, and Figure S1: Maximum parsimony tree based combined ITS region and D1/D2 domains of the LSU rDNA sequences for strains from frost-columnar colonies and other species of Glaciozyma.
Author Contributions
Conceptualization, T.H.; data curation, T.H.; format analysis, S.F., M.I., E.K. and Y.H.; funding acquisition, T.H.; investigation, S.F., M.I., Y.H., E.K. and M.Y.; methodology, T.H., Y.H. and M.Y.; project administration, T.H. and S.K.; resources, T.H., S.K. and S.F.; supervision, T.H.; validation, M.I. and E.K.; visualization, T.H.; writing—original draft, S.F (Master thesis in Graduate School of Sciences, Hokkaido University, in Japanese) and T.H.; writing—review and editing, T.H., M.Y. and S.K. All authors have read and agreed to the published version of the manuscript.
Funding
This research is a part of the Scientific Program of JARE-48. It was supported by NIPR under MEXT in Japan.
Institutional Review Board Statement
Not applicable.
Informed Consent Statement
Not applicable.
Data Availability Statement
Master thesis of S.F. were kept in the library, Faculty of Science/Graduate School of Science/School of Science, Hokkaido University, Sapporo, Japan.
Acknowledgments
The authors are grateful to Naoyuki Matsumoto, Fellow, National Agriculture and Food Research Organization, Japan for improving the manuscript.
Conflicts of Interest
The authors declare no conflict of interest. The funders had no role in the design of the study; in the collection, analyses, or interpretation of data; in the writing of the manuscript, or in the decision to publish the results.
References
- Onofri, S.; Zucconi, L.; Tosi, S. Continental Antarctic Fungi; IHW Verlag: München, Germany, 2007. [Google Scholar]
- Fell, J.W.; Scorzetti, G.; Connell, L.; Craig, S. Biodiversity of micro-eukaryotes in Antarctic Dry Valley soils with <5% soil moisture. Soil Biol. Biochem. 2006, 38, 3107–3119. [Google Scholar]
- Tsuji, M. An index of fungi recorded from the vicinity of Syowa Station. Mycoscience 2018, 59, 319–324. [Google Scholar] [CrossRef]
- Tsuji, M. Genetic diversity of yeasts from East Ongul Island, East Antarctica and their extracellular enzymes secretion. Polar Biol. 2017, 41, 249–258. [Google Scholar] [CrossRef]
- Tsuji, M. An Index of Non-Lichenized Fungi Recorded in the Vicinity of Syowa Station, East Antarctica. In Fungi in Polar Regions; Informa UK Limited: London, UK, 2019; pp. 1–16. [Google Scholar]
- Tsuji, M.; Kudoh, S. Soil Yeasts in the Vicinity of Syowa Station, East Antarctica: Their diversity and extracellular enzymes, cold adaptation strategies, and secondary metabolites. Sustainability 2020, 12, 4518. [Google Scholar] [CrossRef]
- Canini, F.; Geml, J.; D’Acqui, L.; Buzzini, P.; Turchetti, B.; Onofri, S.; Ventura, S.; Zucconi, L. Fungal diversity and functionality are driven by soil texture in Taylor Valley, Antarctica. Fungal Ecol. 2021, 50, 101041. [Google Scholar] [CrossRef]
- Canini, F.; Geml, J.; Buzzini, P.; Turchetti, B.; Onofri, S.; D’Accqui, L.P.; Ripa, C.; Zucconi, L. Growth forms and functional guilds distribution of soil fungi in coastal versus lnland sites of Victoria Land, Anatrctica. Biology 2021, 10, 320. [Google Scholar] [CrossRef]
- de Menezes, G.C.A.; Câmara, P.E.A.S.; Pinto, O.H.B.; Carvalho-Siva, M.; Oliveira, F.S.; Souza, C.D.; Schaefer, C.E.G.R.; Convery, P.; Rosa, C.A.; Rosa, L.H. Fungal diversity present on rocks from a polar desert in continental Antarctica assessed using DNA metabardoding. Extremophiles 2021, 25, 193–202. [Google Scholar] [CrossRef]
- Hoshino, T.; Xiao, N.; Yajima, Y.; Kida, K.; Tokura, K.; Murakami, R.; Tojo, M.; Matsumoto, N. Ecological Strategies of Snow Molds to Tolerate Freezing Stress. In Plant and Microbe Adaptations to Cold in a Changing World; Springer: Berlin/Heidelberg, Germany, 2013; pp. 285–292. [Google Scholar]
- Hoshino, T.; Kiriaki, M.; Ohgiya, S.; Fujiwara, M.; Kondo, H.; Nishimiya, Y.; Yumoto, I.; Tsuda, S. Antifreeze proteins from snow mold fungi. Can. J. Bot. 2003, 81, 1175–1181. [Google Scholar] [CrossRef]
- Amato, P.; Doyle, S.; Christner, B.C. Macromolecular synthesis by yeasts under frozen conditions. Environ. Microbiol. 2009, 11, 589–596. [Google Scholar] [CrossRef] [PubMed]
- Panikov, N.S. Subsero activity of cold-adapted yeasts. In Cold-Adapted Yeast; Buzzini, P., Margesin, R., Eds.; Springer: Berlin/Heidelberg, Germany, 2014; pp. 294–323. [Google Scholar]
- Buzzini, P.; Turk, M.; Perini, L.; Turchetti, B.; Gunde-Cimerman, N. Yeasts in Polar and Subpolar Habitats. In Yeasts in Natural Ecosystems: Diversity; Buzzini, P., Lachance, M.A., Yurkov, A., Eds.; Springer: Berlin/Heidelberg, Germany, 2017; pp. 331–365. [Google Scholar]
- Sannino, C.; Tasselli, G.; Filippucci, S.; Turchetti, B.; Buzzini, P. Yeasts in Nonpolar Cold Habitats. In Yeasts in Natural Ecosystems: Diversity; Buzzini, P., Lachance, M.A., Yurkov, A., Eds.; Springer: Berlin/Heidelberg, Germany, 2017; pp. 367–396. [Google Scholar]
- Deegenaars, M.L.; Watson, K. Heat shock response in psychrophilic and psychrotrophic yeast from Antarctica. Extremophiles 1998, 2, 41–50. [Google Scholar] [CrossRef] [PubMed]
- Maggi, O.; Tosi, S.; Angelova, M.; Lagostina, E.; Fabbri, A.A.; Pecoraro, L.; Altobelli, E.; Picco, A.M.; Savino, E.; Branda, E.; et al. Adaptation of fungi, including yeasts, to cold environments. Plant Biosyst. Int. J. Deal. Asp. Plant Biol. 2013, 147, 247–258. [Google Scholar] [CrossRef]
- Tsuji, M. Cold-stress responses in the Antarctic basidiomycetous yeast Mrakia blollopis. R. Soc. Open Sci. 2016, 3, 160106. [Google Scholar] [CrossRef] [PubMed] [Green Version]
- Su, Y.; Jiang, X.; Wu, W.; Wang, M.; Hamid, M.I.; Xiang, M.; Liu, X. Genomic transcriptomic, and proteomic analysis provide insights into the cold adaptation mechanism of obligate psychrophilic fungus Mrakia psychrohila. G3 2016, 6, 3603–3613. [Google Scholar] [CrossRef] [PubMed] [Green Version]
- Xiao, N.; Inaba, S.; Tojo, M.; Degawa, Y.; Fujiu, S.; Hanada, Y.; Kudoh, S.; Hoshino, T. Antifreeze activities of various fungi and Stramenopila isolated from Antactica. N. Am. Fungi 2010, 5, 215–220. [Google Scholar]
- Hashim, N.H.F.; Bharudin, I.; Nguong, D.L.S.; Higa, S.; Abu Bakar, F.D.; Nathan, S.; Rabu, A.; Kawahara, H.; Illias, R.M.; Najimudin, N.; et al. Characterization of Afp1, an antifreeze protein from the psychrophilic yeast Glaciozyma antarctica PI12. Extremophiles 2013, 17, 63–73. [Google Scholar] [CrossRef] [PubMed]
- Hashim, N.H.F.; Sulaiman, S.; Baker, F.D.A.; Illias, R.M.; Kawahara, H.; Najimudin, N.; Mahadi, N.M.; Murad, A.M.A. Mo-lecular cloning, expression and characterization of Afp4, an antifreeze protein from Glacozyma antarctica. Polar Biol. 2014, 37, 1495–1505. [Google Scholar] [CrossRef]
- Lee, J.K.; Park, A.K.; Do, H.; Park, K.S.; Moh, A.H.; Kang, S.-H.; Kim, H.J. An extracellular ice-binding glycoprotein from an Arctic yeast. Cryobiology 2010, 50, 222–228. [Google Scholar] [CrossRef] [PubMed]
- Villarreal, P.; Carrasco, M.; Barahona, S.; Alcaíno, J.; Cifuentes, V.; Baeza, M. Antarctic yeasts: Analysis of their freeze-thaw tolerance and production of antifreeze proteins, fatty acids and ergosterol. BMC Microbiol. 2018, 18, 1–10. [Google Scholar] [CrossRef]
- Singh, P.; Singh, S.M.; Tsuji, M.; Prasad, G.S.; Hoshino, T. Rhodotorula svalbardensis sp. nov., a novel yeast species isolated from cryoconite holes of Ny-Ålesund, Arctic. Cryobiology 2014, 68, 122–128. [Google Scholar] [CrossRef]
- Tsuji, M.; Kudoh, S.; Hoshino, T.; Isojärvi, J.; Shunmugam, S.; Sivonen, K.; Allahverdiyeva, Y.; Aro, E.-M.; Battchikova, N. Draft Genome Sequence of Cryophilic Basidiomycetous Yeast Mrakia blollopis SK-4, Isolated from an Algal Mat of Naga-ike Lake in the Skarvsnes Ice-Free Area, East Antarctica. Genome Announc. 2015, 3, e01454-14. [Google Scholar] [CrossRef] [Green Version]
- Hoshino, T.; Terami, F.; Tkachenko, O.B.; Tojo, M.; Matsumoto, N. Mycelial growth of the snow mold fungus, Sclerotinia borealis, improved at low water potentials: An adaption to frozen environment. Mycoscience 2010, 51, 98–103. [Google Scholar] [CrossRef]
- Gardes, M.; Bruns, T.D. ITS primers with enhanced specificity for basidiomycetes-application to the identification of mycor-rhizae and rusts. Mol. Ecol. 1993, 2, 113–118. [Google Scholar] [CrossRef] [PubMed]
- White, T.J.; Bruns, T.; Lee, S.; Taylor, J. Amplification and direct sequencing of fungal ribosomal RNA genes for phylogenetics. In PCR Protocols: A Guide to Methods and Applications; Innis, M.A., Gelfand, D.H., Sninsky, J.J., White, T.J., Eds.; Academic Press: New York, NY, USA, 1990; pp. 315–322. [Google Scholar] [CrossRef]
- Kurtzman, C.P.; Robnett, C.J. Identification and phylogeny of ascomycetous yeasts from analysis of nuclear large subunit (26S) ribosomal DNA partial sequences. Antonie Leeuwenhoek 1998, 73, 331–371. [Google Scholar] [CrossRef] [PubMed]
- Kumar, S.; Stecher, G.; Li, M.; Knyaz, C.; Tamura, K. MEGA X: Molecular Evolutionary Genetics Analysis across Computing Platforms. Mol. Biol. Evol. 2018, 35, 1547–1549. [Google Scholar] [CrossRef] [PubMed]
- Yoshida, M.; Abe, J.; Moriyama, M.; Kuwabara, T. Carbohydrate levels among winter wheat cultivars varying in freezing tolerance and snow mold resistance during autumn and winter. Physiol. Plant. 1998, 103, 8–16. [Google Scholar] [CrossRef]
- Matsuyama, H.; Kamesaki, T.; Sasaki, R.; Minami, H.; Yumoto, I. Production of two types of exopolysaccharide by Novo-sphingobium rosa. J. Biosci. Bioeng. 2003, 95, 152–156. [Google Scholar] [CrossRef]
- Xiao, N.; Suzuki, K.; Nishimiya, Y.; Kondo, H.; Miura, A.; Tsuda, S.; Hoshino, T. Comparison of functional properties of two fungal antifreeze proteins from Antarctomyces psychrotrophicus and Typhula ishikariensis. FEBS J. 2010, 277, 394–403. [Google Scholar] [CrossRef]
- Laemmli, U.K. Cleavage of structural proteins during the assembly of the head of bacteriophage T4. Nature 1970, 227, 680–685. [Google Scholar] [CrossRef]
- Hoshino, T.; Kiriaki, M.; Nakajima, T. Novel thermal hysteresis proteins from low temperature basidiomycete, Coprinus psychromorbidus. Cryo Lett. 2003, 24, 135–142. [Google Scholar]
- Takamichi, M.; Nishimiya, Y.; Miura, A.; Tsuda, S. Effect of annealing time of an ice crystal on the activity of type III antifreeze protein. FEBS J. 2007, 274, 6469–6476. [Google Scholar] [CrossRef]
- Kachalkin, A.V. Yeasts of the White Sea intertidal zone and description of Glaciozyma litrale sp. nov. Antonie Leeuwenhoek 2014, 105, 1073–1083. [Google Scholar] [CrossRef] [PubMed]
- Fell, J.W.; Statzell, A.C.; Hunter, I.L.; Phaff, H.J. Leucosporidium gen. n., the heterobasidiomycetous stage of several yeasts of the genus Candida. Antonie Leeuwenhoek 1969, 35, 433–462. [Google Scholar] [CrossRef] [PubMed]
- Tsuji, M.; Yokota, Y.; Kudoh, S.; Hoshino, T. Effects of nitrogen concentration and culturing temperature on lipase secretion and morphology of the Antarctic basidiomycetous yeast Mrakia blollopis. Int. J. Res. Eng. Sci. 2014, 2, 49–54. [Google Scholar]
- Firdaus-Raih, M.; Hashim, N.H.F.; Bharudin, I.; Bakar, M.F.A.; Huang, K.K.; Alias, H.; Lee, B.K.B.; Isa, M.N.M.; Mat-Sharani, S.; Sulaiman, S.; et al. The Glaciozyma antartctica genome reveals an array of system that provide sustained responses towards temperature variations in a persistently cold habitat. PLoS ONE 2018, 13, e0189947. [Google Scholar] [CrossRef] [PubMed] [Green Version]
- Krembs, C.; Eicken, H.; Junge, K.; Deming, J.W. High concentrations of exopolymeric substances in Arctic winter sea ice: Implications for the polar ocean carbon cycle and cryoprotection of diatoms. Deep Sea Res. Part I 2002, 49, 2162–2181. [Google Scholar] [CrossRef]
- Kondo, H.; Hanada, Y.; Sugimoto, H.; Hoshino, T.; Garnham, C.P.; Davies, P.L.; Tsuda, S. Ice-binding site of snow mold fungus antifreeze protein deviates from structural regularity and high conservation. Proc. Natl. Acad. Sci. USA 2012, 109, 9360–9365. [Google Scholar] [CrossRef] [Green Version]
Publisher’s Note: MDPI stays neutral with regard to jurisdictional claims in published maps and institutional affiliations. |
© 2021 by the authors. Licensee MDPI, Basel, Switzerland. This article is an open access article distributed under the terms and conditions of the Creative Commons Attribution (CC BY) license (https://creativecommons.org/licenses/by/4.0/).